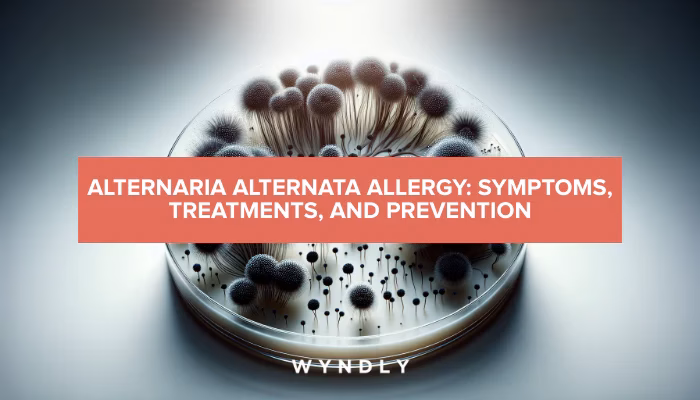
What if I eat Alternaria alternata?

08/11/2010
Forståelse af Alternaria alternata og dens Indvirkning
Alternaria alternata er en af de mest udbredte skimmelsvampe i verden og en hyppig årsag til luftvejsallergier. Den findes både udendørs og indendørs og trives i varme, fugtige miljøer. Udendørs når dens sporer typisk deres højdepunkt i sensommeren og det tidlige efterår, hvor de spredes med tør og varm luft. Indendørs kan svampen findes i fugtige områder som kældre, badeværelser og omkring utætte vinduer, hvilket kan føre til det, der kaldes "syge bygninger-syndrom". For mange mennesker er indånding af disse sporer en direkte vej til allergiske reaktioner, der spænder fra mild høfeber til alvorlig astma. Men hvad mange ikke er klar over, er, at denne luftbårne allergi kan have en overraskende forbindelse til de fødevarer, vi spiser. Denne artikel dykker ned i fænomenet krydsreaktivitet mellem Alternaria alternata og forskellige fødevareallergener.
Symptomer på Allergi over for Alternaria
Allergisymptomer udløst af Alternaria er primært relateret til luftvejene, da eksponering oftest sker ved indånding. De mest almindelige symptomer inkluderer:
- Nysen og løbende eller tilstoppet næse (allergisk rhinitis).
- Kløende, røde og vandige øjne (allergisk conjunctivitis).
- Hoste, hvæsende vejrtrækning og åndenød.
- Forværring af astmasymptomer; Alternaria er kendt for at være en stærk udløser af astmaanfald.
- I nogle tilfælde kan der opstå hudreaktioner som forværring af atopisk eksem.
Fordi svampesporer kan være til stede i luften i lange perioder, kan symptomerne være vedvarende og forveksles med andre allergier som pollen- eller støvmideallergi. En præcis diagnose hos en læge eller allergispecialist er derfor afgørende.
Hvad er Krydsreaktivitet?
Krydsreaktivitet er et immunologisk fænomen, hvor kroppens immunsystem ikke kan skelne mellem lignende proteiner fra forskellige kilder. Når en person er allergisk over for et specifikt allergen, f.eks. et protein i Alternaria-sporer, producerer kroppen IgE-antistoffer mod dette protein. Hvis et protein i en fødevare har en struktur, der minder meget om Alternaria-allergenet, kan disse IgE-antistoffer ved en fejl binde sig til fødevareproteinet og udløse en allergisk reaktion. Reaktionen er ofte mildere end den primære allergi og viser sig typisk som Oralt Allergi Syndrom (OAS), med symptomer som kløe i munden, på læberne og i svælget kort efter indtagelse af den pågældende fødevare.
Alternaria-Spinat Syndromet og Andre Fødevareforbindelser
Den mest velbeskrevne krydsreaktion forbundet med Alternaria-allergi er det såkaldte "Alternaria-Spinat Syndrom". Personer, der er stærkt sensibiliserede over for Alternaria, kan opleve allergiske symptomer, når de spiser spinat. Dette skyldes, at visse proteiner i spinat har en strukturel lighed med allergener i svampen.
Udover spinat er der også rapporteret om krydsreaktioner med andre fødevarer, herunder:
- Spiselige svampe: Da svampe biologisk er beslægtede, er det ikke overraskende, at der kan være krydsreaktive proteiner.
- Tomater og meloner: Disse planter kan være værter for Alternaria, men der kan også være tale om reel krydsreaktivitet mellem planteproteiner og svampeallergener.
Det er vigtigt at understrege, at ikke alle med Alternaria-allergi vil reagere på disse fødevarer. Reaktionen afhænger af, hvilke specifikke allergener man er sensibiliseret over for.

De Specifikke Proteiner Bag Krydsreaktionen
Forskning har identificeret flere specifikke allergenproteiner i Alternaria alternata, hvoraf nogle er kendte for at have homologer (lignende proteiner) i andre organismer, herunder fødevarer. Hovedallergenet, Alt a 1, er unikt for svampe i Pleosporaceae-familien, men andre mindre allergener er mere udbredte panallergener.
Nedenstående tabel giver et overblik over nogle af de vigtigste allergener fra Alternaria og deres potentiale for krydsreaktivitet med fødevarer og andre kilder.
| Allergen-protein (Alternaria) | Proteintype | Potentielle Krydsreaktive Kilder (inkl. fødevarer) |
|---|---|---|
| Alt a 6 | Enolase | Kylling, fisk (laks, tun), gær, andre skimmelsvampe (Cladosporium, Aspergillus), nogle græspollen. |
| Alt a 14 | Mangan Superoxid Dismutase (MnSOD) | Mandler, gær, andre svampe. |
| Alt a 3 | Varmeshokprotein (HSP70) | Gær, Penicillium-svamp, støvmider. |
| Alt a 13 | Glutathion-S-transferase (GST) | Støvmider, kakerlakker, birkepollen. |
Denne viden er særligt vigtig i forbindelse med moderne allergidiagnostik. Ved hjælp af Komponent-Resolut Diagnostik (CRD) kan læger teste for IgE-antistoffer mod specifikke allergenmolekyler i stedet for blot hele svampeekstrakten. Dette giver et meget mere detaljeret billede af patientens sensibiliseringsprofil og kan hjælpe med at forudsige risikoen for krydsreaktioner.
Diagnose og Håndtering
Hvis du har mistanke om, at du lider af en allergi over for Alternaria, eller hvis du oplever symptomer efter at have spist bestemte fødevarer, er det første skridt at konsultere en læge. Diagnosen stilles typisk gennem en kombination af sygehistorie, en priktest og/eller en blodprøve, der måler specifikke IgE-antistoffer.
Håndtering af Allergi og Krydsreaktioner
- Undgåelse af Eksponering: Den mest effektive strategi er at minimere kontakten med Alternaria-sporer. Hold luftfugtigheden indendørs under 50%, reparer eventuelle vandskader, sørg for god ventilation, og brug et HEPA-filter i støvsugeren og eventuelt en luftrenser. Udendørs kan det være en god idé at holde vinduerne lukkede på dage med høje sporeniveauer.
- Medicinsk Behandling: Symptomer kan behandles med antihistaminer, næsespray med kortikosteroider og øjendråber. For astmapatienter er det afgørende at følge den ordinerede behandlingsplan.
- Allergivaccination (Immunterapi): For personer med alvorlig eller vedvarende allergi kan immunterapi være en mulighed. Denne behandling sigter mod at gøre immunsystemet mere tolerant over for allergenet over tid.
- Håndtering af Fødevarereaktioner: Hvis du oplever krydsreaktioner, er løsningen at undgå de udløsende fødevarer. Da reaktionerne ofte er milde, kan det for nogle være tilstrækkeligt at undgå rå versioner af fødevarerne, da opvarmning kan nedbryde de allergifremkaldende proteiner. Tal altid med din læge eller en diætist, før du foretager store ændringer i din kost.
Ofte Stillede Spørgsmål (FAQ)
Kan jeg spise spinat, hvis jeg har Alternaria-allergi?
Ikke alle med Alternaria-allergi reagerer på spinat. Det afhænger af din individuelle sensibiliseringsprofil. Hvis du ikke oplever symptomer som kløe i munden eller svælget efter at have spist spinat, er der sandsynligvis ingen grund til at undgå det. Hvis du er i tvivl, så tal med din læge.

Er Alternaria alternata farlig?
For de fleste mennesker er svampen harmløs. For personer med allergi er den dog en betydelig kilde til ubehag og en alvorlig trigger for astma. I meget sjældne tilfælde kan den forårsage infektioner hos personer med stærkt svækket immunforsvar, men dette er ikke relateret til allergi.
Hvad er forskellen på en skimmelsvampallergi og en pollenallergi?
Symptomerne er meget ens, men kilderne og sæsonerne kan variere. Pollenallergi er strengt sæsonbestemt (f.eks. forår for birk, sommer for græs). Skimmelsvampallergi kan være helårlig, hvis kilden er indendørs, eller have en top i sensommeren og efteråret, hvilket kan overlappe med f.eks. bynkepollen. En præcis diagnose kræver specifikke allergitest.
Hvordan kan jeg reducere skimmelsvamp i mit hjem?
Nøglen er fugtkontrol. Brug emhætte under madlavning og ventilator på badeværelset. Tør ikke tøj indendørs. Sørg for at udbedre utætheder og hold generelt en lav luftfugtighed. Regelmæssig rengøring, især i fugtige områder, er også vigtigt.
Afslutningsvis er Alternaria alternata mere end blot en årsag til høfeber og astma. Forståelsen af dens potentiale for krydsreaktivitet med fødevarer åbner for en dybere indsigt i de komplekse mekanismer bag allergier. Ved at være opmærksom på disse skjulte forbindelser kan personer med allergi, i samråd med deres læge, bedre håndtere deres symptomer og forbedre deres livskvalitet.
Hvis du vil læse andre artikler, der ligner Alternaria-allergi: Krydsreaktion med fødevarer, kan du besøge kategorien Allergi.
